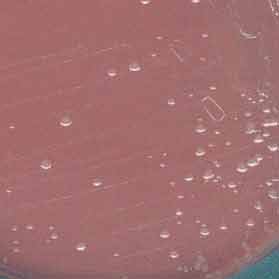

- Voici l'aspect de la culture sur une gélose chocolat Polyvitex® après 48 heures d'incubation à 37°C en atmosphère contrôlée (10% de gaz carbonique) :

- Voici deux aspects des colonies sur la gélose au sang cuit (à gauche) et celle au sang frais (à droite) après 48 heures d'incubation à 37°C sous CO2 :
|
 |
- Voici l'aspect morphologique de ce germe après une coloration de Gram :

- Le test d'orientation rapide avec le disque OXY (oxydase) est recherché comme ci-dessous après 20 secondes de contact:

- Les caractères d'identification de ce germe sont recherchés à l'aide d'une galerie d'identification biochimique API ci-dessous après 18 h d'incubation à 37°C:
|
|
|
|
|
